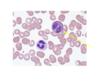
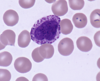
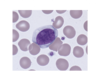

Introduction to Haematology System, Constituents of Blood and Haemopoiesis 2 Flashcards
(17 cards)
What type of cell is shown and what are its characterisitc features ?
Eosinophil:
- Usually bi-lobed
- Bright orange/red staining granules
What is the function of eosinophils ?
- Fight parasitic infections
- Involved in hypersensitivity (allergic reactions) - Often elevated in patients with allergic conditions (e.g. asthma, atopic rhinitis)
What type of cell is shown and what is its characterisitc features ?
Basophil:
- Characterisitically has large deep purple granules obscuring nucleus (note if unstained then it does usually have a bi-lobed nucleus)
What is the function of basophils?
- Circulating version of tissue mast cell
- Exact physiological function unknown but thought to mediate hypersensitivity reactions as when its IgE binds to its Fc receptors they release histamine (its granules contain histamine)
Are basophils commonly found in the circulation ?
No - they are uncommon
What type of cell is shown and what are its characterisitc features ?

Monocyte:
- Large single nucleus
- Faintly staining granules, often vacuolated
Pic shows Monocyte with pale blue cytoplasm and fine granulation (you can also see the white holes these are the vacuoles)
What type of cell do monocytes develop into and where does this occur ?
Monocytes are found in the circulation (can remain there for upto a week) they then move into the tissues where they become macrophages
What is the function of monocytes ?
To move into tissues and then:
Phagocyose invaders
- Kill them
- Present antigen to lymphocytes
- Attract other cells
Which type of cell can remain in the tissues for longer, neutrophils or macrophages ?
Macrophages - they can remain there for many years
What are the main subtypes of lymphocytes ?
B, T lymphocyes and NK cells
What are the 2 main appearances of lymphocytes seen ?
- Mature (circulating) lymphocytes
- Atypcial (activated) lymphocytes
What type of lymphocyte is shown and what are its characterisitc features ?

- Mature (circulating) lymphocytes
- Small cell (not much bigger than an erythrocyte as seen in pic) with condensed dark staining nucleus and small rim of cytoplasm
What type of lymphocyte is shown and what are its characterisitc features ?
- Atypical (activated) lymphocyte
- Large (can see how much bigger it is now compared to erythrocytes in pic) with plentiful blue cytoplasm extending round neighbouring red cells on the film, nucleus more ‘open’ structure
What is lymphocyte production often increased due to ?
- Viral infections particularly - infectious mononucleosis (EBV), CMV, HIV
- Also chronic infections
What technique is mainly used to identify more primitive precursors (as remember stem cells etc dont have morphological features which can be used to distinguish them)
Immunophentyping looking at the expression profile of proteins (antigens) on the surface of cells
In general how is the haematopoietic system investigated ?
- Look at the peripheral blood - through blood films (to look at morphological appearance of cells) and automated cell counters (these look at the blood, and quantify, classify, and describe cell populations using both electrical and optical techniques)
- Look at the bone marrow - bone marrow biopsy
- Specialised tests of bone marrow
- Look at other sites of relevance to blood production e.g. splenomegaly, hepatomegaly, lymphadenopathy.
What are the common sites for bone marrow biopsy ?
- PSIS in adults
- Tibia in neonates



